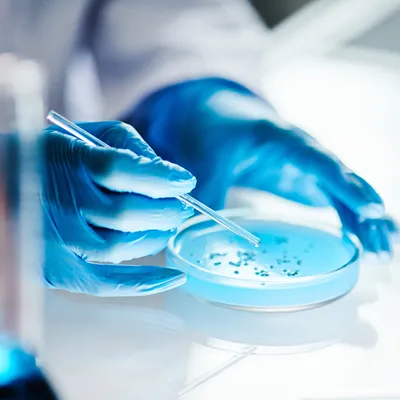

Alumina / Zirconia / Silicon Nitride / Silicon Carbide
Premium Grinding Ball Promotion | Performance and Value Value-Added Services: Free Sample Kit & Technical Consultation
 Limited-Time Offer: 11/15-12/31
Limited-Time Offer: 11/15-12/31
Hot Sale Models
Cost-Effective Alumina Grinding Balls
Diameter: Φ3 mm, Φ5 mm, Φ10 mm, Φ15 mm, etc.
Your Go-To Choice for Precision Grinding:
Plance an order for Instant Discounts:
Purity: 99%
Thermal Conductivity (20℃) W/(m·k): 30
High-Purity Zirconia Grinding Balls
For Precision Grinding & Zero Contamination :
Purity: 94.6%
Composition (%): 94.6% ZrO2 5.4% Y2O3
Features: Good stability, strong acid resistance, and alkali proof